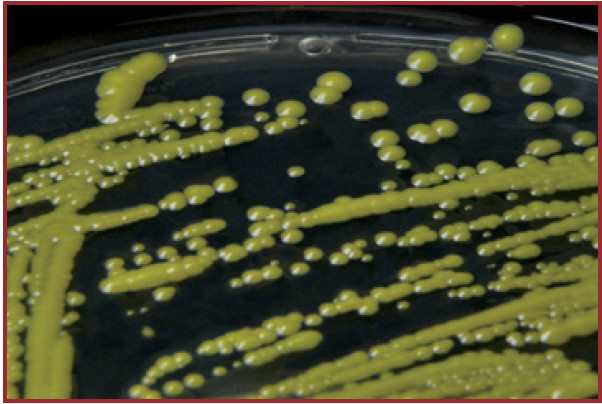

- These colonies are yellow, smooth, and convex with a regular margin.
- They range in size from 1 to 3 mm. M. luteus is common in soil, dust, and on human skin.
© 2026 Medical Laboratories. All rights reserved. Site Admin · ·
Powered by WordPress · Powered by Medical Labs